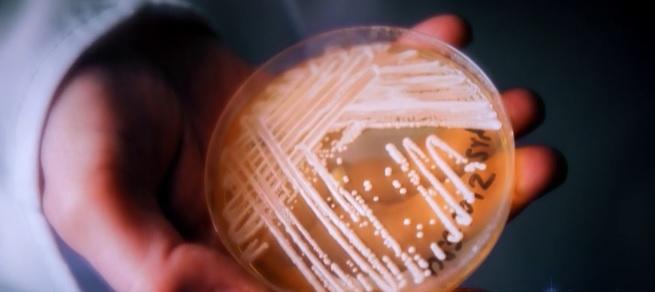

事發的比勒魯德紙廠。(互聯網)

美國密歇根州一間紙廠近日爆發芽生真菌病(blastomycosis)疫情,2月至今累計近百宗病例,其中一人死亡。患者因吸入芽生真菌孢子致病,出現咳嗽、發燒等類似肺炎症狀。衛生官員斯奈德指,衛生部每年均接獲少數芽生真菌感染病例,但如此大型爆發實屬罕見。威斯康辛州上月也有一波疫情,至少4人發病,一人死亡。
綜合美聯社與美國廣播公司(ABC)等媒體報道,事發於密州北部、聘用逾800名員工的比勒魯德紙廠(Billerud Paper Mill),衛生當局上周五公布,首宗個案於2月28日通報,衛生部門隨後於3月展開調查,至今最少21人確診,其中12人住院,一人死亡,另有76宗懷疑個案,所有人都是紙廠員工或訪客,廠房需關閉3周徹底消毒。


電子顯微鏡下的芽生真菌孢子。(互聯網)
孢子入侵肺部 擴散全身
疾控中心(CDC)指,近半數患者吸入芽生真菌孢子後出現病徵,初期症狀與呼吸道疾病相同,如發燒、咳嗽、胸痛、肌肉痛、怠倦、呼吸困難等,診斷不易。潮濕泥土或木材樹葉腐爛的環境有利芽生真菌大量繁殖並生出孢子。
專家表示,人們若吸入,部分孢子可能避過免疫系統,從肺部擴散至關節、骨骼、腦部、脊椎等部位。吸入孢子後3周至3個月之間可能發病,不會人傳人,但可能致命,其中免疫力較弱或未能早期診治的人,死亡風險較高。
美國病例多見於中西部
芽生真菌感染主要在美加出現,但病例不多,2019年全美通報240例。美國常見於如密歇根、明尼蘇達及威斯康辛等中西部州份、大湖區和西南部,密歇根州過去5年每年平均僅26例。
美國密歇根州一間紙廠爆發芽生真菌感染疫情。(互聯網)
















